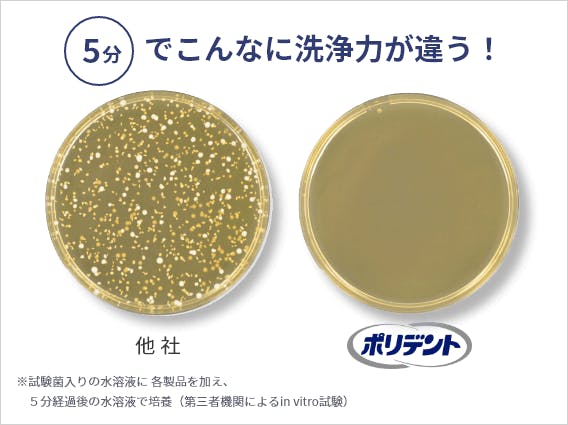
５分洗浄後の他社とのシャーレ―の除菌画像

ポリデントの洗浄力はなにが違うのか?
POINT
ポリデントの4つの違い
01
強力発泡でミクロな
汚れや菌まで徹底洗浄
ポリデント洗浄剤は素早く溶け、
たった5分で隅々まで徹底洗浄。
入れ歯を毎日清潔に保ちます。

Movie


02
⻭科医推奨No.1
しっかり強⼒洗浄できる「ポリデント」は、
⻭科医師からも⽀持を得て、
推奨する⼊れ⻭洗浄剤No.1として選ばれています。
※義⻭洗浄剤内。当社が第三者調査機関へ委託し
⻭科医師サンプル200名へ2024年6月に実施した定量調査に基づく。
Movie

03
55年以上の
歴史と信頼
アメリカ、ヨーロッパ、アジアなど世界中でも
幅広いご支持をいただいております。

04
豊富なラインナップ
ラインナップをリニューアルしました。
ポリデントは部分入れ歯から総入れ歯までお悩みに応じた
豊富なラインナップをご用意しています。
みなさまの気になるお悩みに応じた製品をお選びください。
HOW TO
使い方動画のご紹介



















